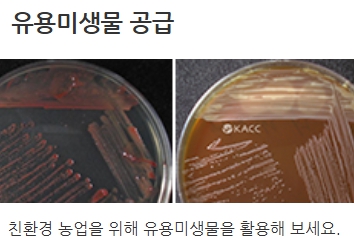

농업기술센터는 지역 농업인의 기술적 지원을 위해 다양한 프로그램과 정보를 제공하는 중요한 기관입니다.
특히, 각 지역별 농업기술센터는 농업기술 교육, 농기계 대여, 농업 정보 제공 등을 통해 농업인들의 영농 활동을 돕고 있습니다.
이번 글에서는 농업기술센터 홈페이지에서 제공하는 다양한 서비스와 활용 방법을 소개하겠습니다.
1. 농업기술 교육과 체험 프로그램




농업기술센터 홈페이지는 다양한 농업 교육 프로그램과 체험 활동을 제공하고 있습니다.
예를 들어, 서울특별시 농업기술센터에서는 도시농업 관련 프로그램부터 귀농 귀촌 교육까지 다양한 교육 과정이 운영됩니다.
특히, 반려식물 관리, 치유농업, 텃밭 가꾸기 등 현대 도시인들을 위한 프로그램도 제공하고 있어, 농업에 관심 있는 사람들이 쉽게 접근할 수 있습니다.
이 교육들은 온라인으로도 신청이 가능하며, 각 지역 센터에서 실습 형태로 진행되기도 합니다.
2. 농기계 대여 및 지원 사업



농업기술센터에서는 농업인을 대상으로 농기계를 대여해주는 서비스도 제공합니다.
농기계는 구매 비용이 많이 들기 때문에 소규모 농업인에게는 큰 도움이 됩니다.
각 지역 농업기술센터에서는 농기계 대여뿐만 아니라 농기계 사용법에 대한 교육도 진행하고 있어 농업 효율을 높이는 데 기여하고 있습니다.
천안시 농업기술센터의 경우, 다양한 기종의 농기계를 대여할 수 있으며, 지역별로 신청 절차와 대여 가능한 기계 목록이 홈페이지에 제공됩니다.
3. 농업 정보 제공과 영농 상담

농업기술센터 홈페이지는 농업 관련 최신 정보도 제공합니다.
농산물 가격 동향, 기상 정보, 병해충 발생 경보 등 실시간으로 제공되는 정보는 농업인들이 영농 활동을 계획하고 관리하는 데 큰 도움이 됩니다.
예를 들어, 안성시 농업기술센터에서는 병해충 발생 정보를 실시간으로 제공하여 농업인이 신속히 대응할 수 있도록 지원하고 있습니다.
또한, 농업 관련 질문을 홈페이지를 통해 상담할 수 있어, 영농에 어려움을 겪는 농업인들이 문제를 해결할 수 있는 창구를 마련하고 있습니다.
4. 귀농귀촌 지원 프로그램




귀농과 귀촌을 꿈꾸는 사람들을 위해 농업기술센터는 다양한 지원 프로그램을 운영합니다.
서울특별시 농업기술센터는 귀농귀촌 희망자들을 위한 맞춤형 교육과정과 상담을 제공하고 있으며, 농업기술뿐만 아니라 농촌 생활 적응을 위한 실질적인 정보를 제공합니다.
이를 통해 도시에서 농촌으로 이주하는 사람들이 농업에 안정적으로 정착할 수 있도록 돕고 있습니다.
더불어 농업 관련 자금 및 보조금 신청에 대한 정보도 제공하여 귀농 계획을 세우는 데 큰 도움이 됩니다.
농업기술센터 홈페이지는 농업인과 예비 농업인들에게 유용한 정보와 서비스를 제공하는 중요한 플랫폼입니다.
농업 교육, 농기계 대여, 최신 농업 정보 등 다양한 서비스를 통해 농업인들이 보다 효과적으로 농업 활동을 할 수 있도록 돕고 있습니다.
농업에 관심이 있거나 귀농을 꿈꾸는 분들은 각 지역의 농업기술센터 홈페이지를 통해 필요한 정보를 쉽게 얻을 수 있으니, 적극적으로 활용해 보시길 권장드립니다.
📢 같이보면 유용한 글
현대해상 실비보험 청구방법│서류│기간
현대해상 실비보험은 예기치 않은 의료비 발생 시 경제적 부담을 덜어주는 필수적인 보험 상품입니다. 많은 사람들이 실비보험을 통해 의료비를 보상받고 있지만, 보험금 청구 절차를 복잡하
money.moneyenter.com
삼성화재 다이렉트 자동차보험 긴급출동 고객센터 전화번호
삼성화재 다이렉트 자동차보험 긴급출동 고객센터 전화번호
삼성화재 다이렉트 자동차보험은 합리적인 보험료와 더불어 신속한 긴급출동 서비스를 제공해 많은 운전자들에게 선택받고 있는 보험 상품입니다. 긴급 상황에서의 빠른 대응은 매우 중요한
money.moneyenter.com
보험가입내역 일괄조회 서비스 바로가기
보험은 미래의 불확실성에 대비해 중요한 재정 도구이지만, 여러 보험사에 분산되어 있는 내 보험 가입 내역을 모두 기억하고 관리하는 것은 쉽지 않습니다. 특히, 오랜 시간 동안 잊고 있었던
money.moneyenter.com